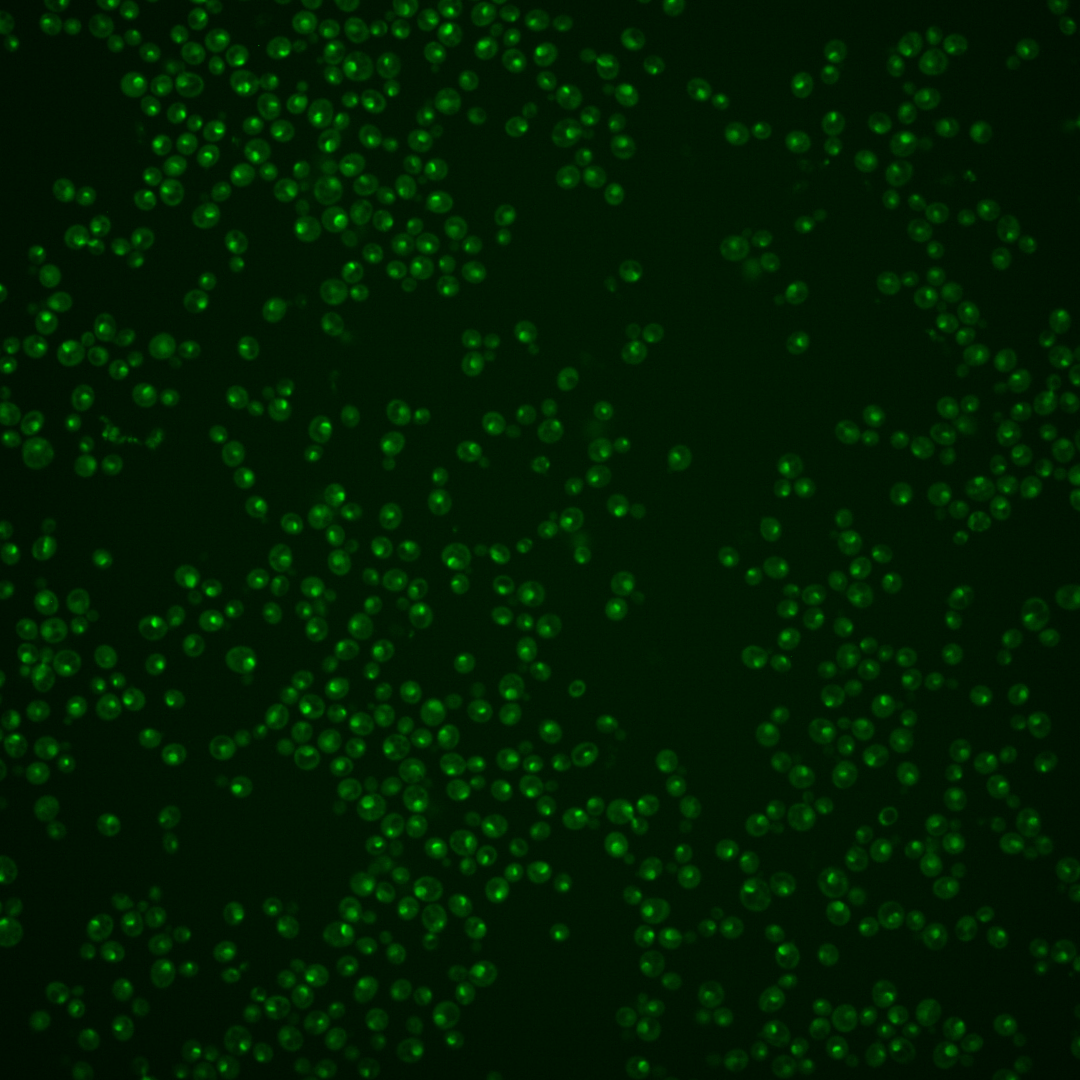
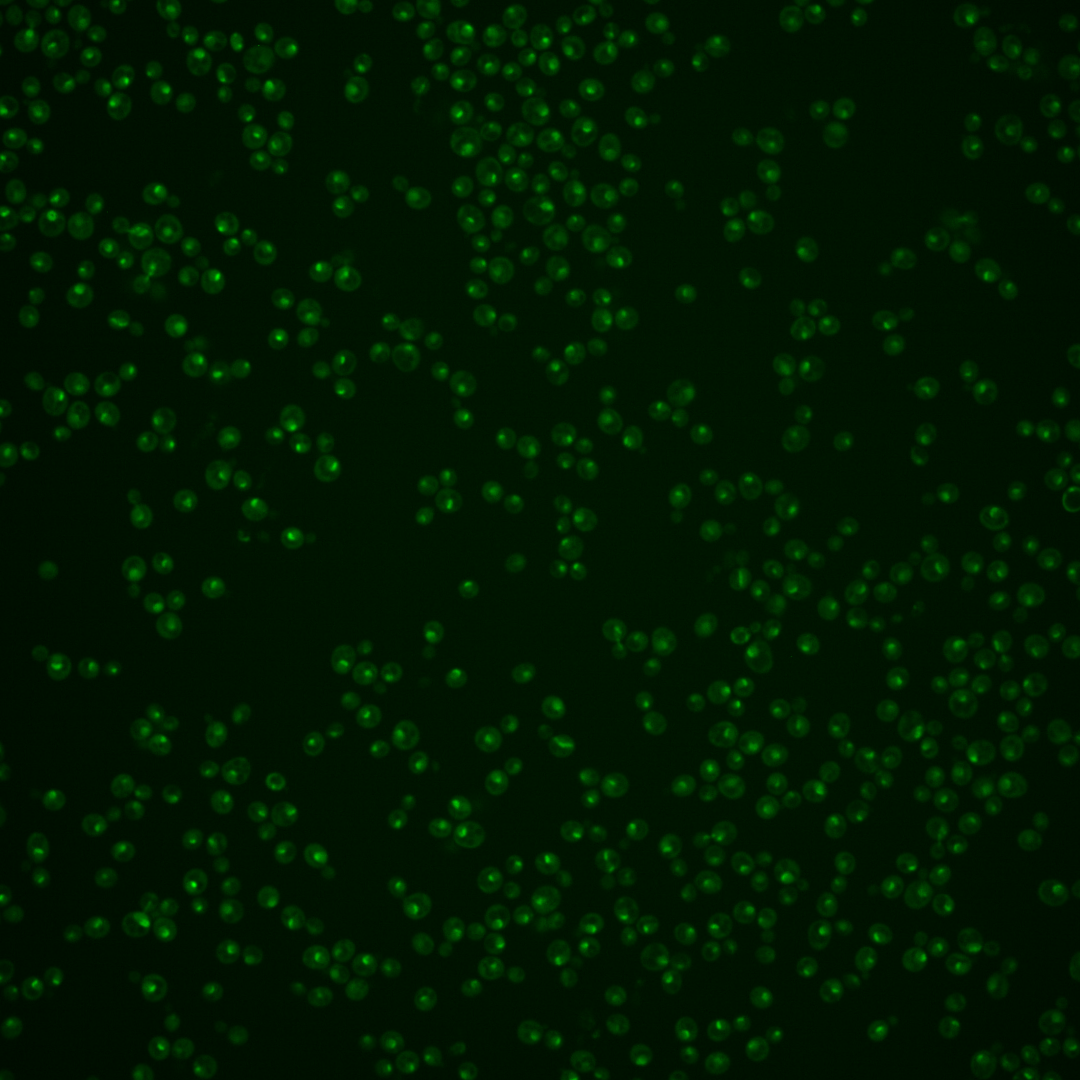

| Standard name | |
|---|---|
| Human Ortholog | |
| Description | Predominantly nucleolar DEAH-box ATP-dependent RNA helicase; required for 18S rRNA synthesis |
Micrographs




















































































Sub-cellular Localization
Yeast GFP Assignment
Protein Abundance
Localization Change
External localization resources
| ensLOC | DeepLoc | |||||||||||||||||||||||
|---|---|---|---|---|---|---|---|---|---|---|---|---|---|---|---|---|---|---|---|---|---|---|---|---|
| Localization | WT1 | WT2 | WT3 | RAP60 | RAP140 | RAP220 | RAP300 | RAP380 | RAP460 | RAP540 | RAP620 | RAP700 | HU80 | HU120 | HU160 | rpd3Δ_1 | rpd3Δ_2 | rpd3Δ_3 | WT1 | WT2 | WT3 | AF100 | AF140 | AF180 |
| Cortical Patches | 0 | 0 | 0 | 0 | 0 | 0 | 0 | 0 | 0 | 1 | 0 | 0 | 0 | 0 | 0 | 0 | 0 | 0 | 0 | 0 | 0 | 0 | 2 | 2 |
| Bud | 0 | 1 | 1 | 1 | 1 | 4 | 9 | 14 | 8 | 15 | 13 | 14 | 0 | 0 | 2 | 0 | 0 | 0 | 1 | 4 | 1 | 1 | 8 | 3 |
| Bud Neck | 0 | 2 | 7 | 2 | 10 | 2 | 21 | 42 | 4 | 14 | 8 | 24 | 0 | 6 | 3 | 1 | 0 | 0 | 1 | 3 | 4 | 2 | 15 | 14 |
| Bud Site | 1 | 1 | 0 | 1 | 4 | 7 | 16 | 6 | 31 | 18 | 20 | 23 | 1 | 1 | 1 | 0 | 0 | 0 | – | – | – | – | – | – |
| Cell Periphery | 0 | 0 | 0 | 0 | 0 | 0 | 0 | 1 | 1 | 0 | 0 | 0 | 0 | 0 | 0 | 1 | 0 | 0 | 0 | 0 | 0 | 0 | 0 | 0 |
| Cytoplasm | 3 | 2 | 5 | 9 | 10 | 17 | 15 | 23 | 13 | 32 | 21 | 27 | 11 | 45 | 81 | 2 | 4 | 7 | 0 | 0 | 2 | 1 | 1 | 2 |
| Endoplasmic Reticulum | 0 | 0 | 1 | 0 | 0 | 0 | 0 | 0 | 0 | 0 | 2 | 0 | 0 | 0 | 1 | 2 | 0 | 2 | 0 | 0 | 0 | 2 | 2 | 2 |
| Endosome | 0 | 6 | 0 | 1 | 6 | 20 | 10 | 12 | 0 | 4 | 7 | 7 | 8 | 35 | 62 | 4 | 8 | 7 | 5 | 9 | 10 | 12 | 38 | 53 |
| Golgi | 0 | 0 | 0 | 0 | 0 | 0 | 0 | 0 | 0 | 0 | 0 | 0 | 0 | 0 | 2 | 1 | 0 | 1 | 1 | 0 | 0 | 1 | 5 | 2 |
| Mitochondria | 32 | 34 | 11 | 16 | 11 | 71 | 93 | 49 | 227 | 179 | 206 | 134 | 35 | 20 | 25 | 8 | 0 | 8 | 0 | 1 | 1 | 3 | 3 | 4 |
| Nucleus | 30 | 58 | 104 | 78 | 91 | 65 | 90 | 71 | 65 | 60 | 63 | 67 | 95 | 129 | 140 | 43 | 49 | 42 | 16 | 30 | 37 | 38 | 27 | 23 |
| Nuclear Periphery | 2 | 0 | 0 | 0 | 1 | 0 | 0 | 1 | 0 | 0 | 0 | 0 | 1 | 0 | 1 | 3 | 0 | 1 | 0 | 1 | 1 | 0 | 1 | 2 |
| Nucleolus | 50 | 64 | 13 | 68 | 46 | 77 | 52 | 48 | 58 | 52 | 43 | 37 | 164 | 323 | 354 | 85 | 69 | 80 | 42 | 73 | 101 | 102 | 244 | 190 |
| Peroxisomes | 0 | 1 | 0 | 0 | 0 | 0 | 0 | 2 | 0 | 1 | 0 | 0 | 0 | 3 | 5 | 0 | 0 | 2 | 0 | 0 | 0 | 0 | 4 | 1 |
| SpindlePole | 14 | 32 | 71 | 63 | 98 | 103 | 159 | 194 | 102 | 106 | 77 | 144 | 48 | 179 | 157 | 18 | 23 | 28 | 21 | 20 | 19 | 26 | 138 | 125 |
| Vac/Vac Membrane | 0 | 3 | 0 | 1 | 3 | 5 | 4 | 7 | 2 | 3 | 7 | 6 | 2 | 1 | 4 | 6 | 6 | 3 | 2 | 5 | 9 | 16 | 18 | 21 |
| Unique Cell Count | 80 | 134 | 160 | 152 | 204 | 252 | 321 | 324 | 324 | 329 | 303 | 328 | 252 | 480 | 573 | 134 | 121 | 133 | 95 | 151 | 192 | 210 | 518 | 459 |
| Labelled Cell Count | 132 | 204 | 213 | 240 | 281 | 371 | 469 | 470 | 511 | 485 | 467 | 483 | 365 | 742 | 838 | 174 | 159 | 181 | 95 | 151 | 192 | 210 | 518 | 459 |
Yeast GFP Assignment
Protein Abundance
| Screen | WT1 | WT2 | WT3 | RAP60 | RAP140 | RAP220 | RAP300 | RAP380 | RAP460 | RAP540 | RAP620 | RAP700 | HU80 | HU120 | HU160 | rpd3Δ_1 | rpd3Δ_2 | rpd3Δ_3 | AF100 | AF140 | AF180 |
|---|---|---|---|---|---|---|---|---|---|---|---|---|---|---|---|---|---|---|---|---|---|
| Mean Cell GFP Intensity (1e-4) | 4.6 | 4.8 | 5.3 | 5.2 | 5.7 | 4.3 | 4.3 | 4.6 | 3.5 | 3.6 | 3.4 | 3.8 | 5.5 | 5.4 | 5.3 | 9.0 | 10.1 | 9.3 | 5.1 | 5.1 | 5.4 |
| Std Deviation (1e-4) | 0.6 | 0.7 | 1.0 | 1.3 | 1.4 | 1.2 | 0.8 | 1.2 | 0.7 | 0.7 | 0.8 | 0.7 | 1.2 | 1.1 | 1.2 | 2.5 | 2.5 | 2.3 | 1.1 | 1.2 | 1.4 |
| Intensity Change (Log2) | – | – | – | -0.02 | 0.09 | -0.32 | -0.29 | -0.2 | -0.59 | -0.58 | -0.64 | -0.47 | 0.05 | 0.02 | 0.01 | 0.77 | 0.94 | 0.82 | -0.06 | -0.05 | 0.03 |
Localization Change
| Localization | RAP60 | RAP140 | RAP220 | RAP300 | RAP380 | RAP460 | RAP540 | RAP620 | RAP700 | HU80 | HU120 | HU160 | rpd3Δ_1 | rpd3Δ_2 | rpd3Δ_3 |
|---|---|---|---|---|---|---|---|---|---|---|---|---|---|---|---|
| Actin | – | – | – | – | – | – | – | – | – | – | – | – | – | – | – |
| Bud | – | – | – | – | – | – | – | – | – | – | – | – | – | – | – |
| Bud Neck | – | – | – | – | – | – | – | – | – | – | – | – | – | – | – |
| Bud Site | – | – | – | – | – | – | – | – | – | – | – | – | – | – | – |
| Cell Periphery | – | – | – | – | – | – | – | – | – | – | – | – | – | – | – |
| Cyto | – | – | – | – | – | – | – | – | – | – | – | – | – | – | – |
| Endoplasmic Reticulum | – | – | – | – | – | – | – | – | – | – | – | – | – | – | – |
| Endosome | – | – | – | – | – | – | – | – | – | – | – | – | – | – | – |
| Golgi | – | – | – | – | – | – | – | – | – | – | – | – | – | – | – |
| Mitochondria | – | – | – | – | – | – | – | – | – | – | – | – | – | – | – |
| Nuclear Periphery | – | – | – | – | – | – | – | – | – | – | – | – | – | – | – |
| Nuc | – | – | – | – | – | – | – | – | – | – | – | – | – | – | – |
| Nucleolus | – | – | – | – | – | – | – | – | – | – | – | – | – | – | – |
| Peroxisomes | – | – | – | – | – | – | – | – | – | – | – | – | – | – | – |
| SpindlePole | – | – | – | – | – | – | – | – | – | – | – | – | – | – | – |
| Vac | – | – | – | – | – | – | – | – | – | – | – | – | – | – | – |
External localization resources
Images






























Protein Concentration and Protein Localization Data
| R1 | R2 | R3 | ||||||||||||||||
|---|---|---|---|---|---|---|---|---|---|---|---|---|---|---|---|---|---|---|
| G1 Pre-START | G1 Post-START | S/G2 | Metaphase | Anaphase | Telophase | G1 Pre-START | G1 Post-START | S/G2 | Metaphase | Anaphase | Telophase | G1 Pre-START | G1 Post-START | S/G2 | Metaphase | Anaphase | Telophase | |
| Concentration | 0.5519 | 0.8234 | 0.436 | 0.8201 | 0.2774 | 0.5967 | 0.9362 | 1.424 | 1.0885 | 0.6928 | 1.0096 | 1.1034 | 1.7322 | 2.0221 | 1.4556 | 1.4858 | 1.4791 | 1.4866 |
| Actin | 0.0124 | 0 | 0.0001 | 0.0033 | 0 | 0.0039 | 0.0085 | 0 | 0.0006 | 0 | 0.0005 | 0.0001 | 0.0518 | 0 | 0.0029 | 0 | 0.0431 | 0.0068 |
| Bud | 0.0003 | 0.0001 | 0 | 0.0066 | 0 | 0.0004 | 0.0004 | 0 | 0.0009 | 0 | 0.0003 | 0 | 0.0004 | 0.0001 | 0.0001 | 0.0001 | 0.0008 | 0.0001 |
| Bud Neck | 0.0049 | 0.0012 | 0.0013 | 0.0024 | 0.0013 | 0.0027 | 0.0039 | 0.0004 | 0.0005 | 0.0006 | 0.0009 | 0.0007 | 0.0029 | 0.0014 | 0.0007 | 0.0015 | 0.0013 | 0.0012 |
| Bud Periphery | 0.0006 | 0.0003 | 0.0001 | 0.0175 | 0.0003 | 0.0009 | 0.0006 | 0.0001 | 0.0016 | 0.0001 | 0.0007 | 0.0001 | 0.0006 | 0.0002 | 0.0002 | 0.0004 | 0.0017 | 0.0001 |
| Bud Site | 0.003 | 0.001 | 0.0008 | 0.0216 | 0.0002 | 0.0009 | 0.0055 | 0.0003 | 0.0009 | 0.0002 | 0.0004 | 0.0002 | 0.0055 | 0.0019 | 0.0012 | 0.001 | 0.0019 | 0.0005 |
| Cell Periphery | 0.0003 | 0.0002 | 0.0002 | 0.0012 | 0.0002 | 0.0002 | 0.0007 | 0.0001 | 0.0002 | 0.0001 | 0.0005 | 0.0001 | 0.0005 | 0.0005 | 0.0003 | 0.0009 | 0.0003 | 0.0001 |
| Cytoplasm | 0.0044 | 0.0004 | 0.0013 | 0.0009 | 0 | 0.0003 | 0.0044 | 0 | 0.0006 | 0 | 0.0001 | 0 | 0.0142 | 0 | 0.0001 | 0 | 0.0002 | 0.0002 |
| Cytoplasmic Foci | 0.0136 | 0.001 | 0.0068 | 0.0106 | 0.0006 | 0.0027 | 0.0055 | 0.0004 | 0.0087 | 0.0003 | 0.0111 | 0.0011 | 0.0197 | 0.0005 | 0.0014 | 0.005 | 0.0076 | 0.0035 |
| Eisosomes | 0.0001 | 0 | 0.0001 | 0.0001 | 0 | 0 | 0.0001 | 0 | 0 | 0 | 0.0001 | 0 | 0.0006 | 0 | 0.0001 | 0 | 0.0002 | 0.0001 |
| Endoplasmic Reticulum | 0.0085 | 0.0001 | 0.0003 | 0.0006 | 0 | 0.0004 | 0.003 | 0 | 0.0002 | 0 | 0.0006 | 0 | 0.0016 | 0 | 0.0001 | 0 | 0.0005 | 0.0002 |
| Endosome | 0.0146 | 0.0016 | 0.002 | 0.0174 | 0.0002 | 0.0015 | 0.0146 | 0.0001 | 0.0129 | 0 | 0.0153 | 0.0028 | 0.0135 | 0.0002 | 0.0022 | 0.0016 | 0.0272 | 0.0026 |
| Golgi | 0.0033 | 0.0002 | 0.0006 | 0.0056 | 0.0002 | 0.0006 | 0.0089 | 0.0001 | 0.0064 | 0 | 0.0061 | 0.0035 | 0.0174 | 0.0001 | 0.001 | 0.0007 | 0.0155 | 0.0024 |
| Lipid Particles | 0.0283 | 0.0046 | 0.0308 | 0.0196 | 0.0053 | 0.0121 | 0.0178 | 0.0021 | 0.0126 | 0.0015 | 0.145 | 0.0082 | 0.0444 | 0.0023 | 0.0045 | 0.037 | 0.0298 | 0.0087 |
| Mitochondria | 0.0013 | 0.0007 | 0.0003 | 0.0125 | 0.0006 | 0.0007 | 0.0108 | 0.0001 | 0.0113 | 0.0001 | 0.0922 | 0.001 | 0.0054 | 0.0002 | 0.0101 | 0.0056 | 0.0118 | 0.0146 |
| None | 0.003 | 0.0019 | 0.0042 | 0.0014 | 0.0001 | 0.0002 | 0.0013 | 0 | 0.0001 | 0 | 0.0002 | 0 | 0.0144 | 0 | 0 | 0.0001 | 0.0002 | 0.0013 |
| Nuclear Periphery | 0.0234 | 0.0031 | 0.0039 | 0.0008 | 0.0007 | 0.0016 | 0.0135 | 0.0001 | 0.0002 | 0 | 0.0032 | 0.0001 | 0.0064 | 0.0001 | 0.0001 | 0.0002 | 0.001 | 0.0002 |
| Nucleolus | 0.6622 | 0.7897 | 0.8258 | 0.7635 | 0.7339 | 0.811 | 0.7764 | 0.839 | 0.8542 | 0.9087 | 0.5043 | 0.8874 | 0.672 | 0.8738 | 0.8576 | 0.8231 | 0.644 | 0.8028 |
| Nucleus | 0.1342 | 0.142 | 0.0836 | 0.072 | 0.1381 | 0.0854 | 0.0963 | 0.1468 | 0.0773 | 0.0849 | 0.0853 | 0.0812 | 0.0806 | 0.1062 | 0.1036 | 0.1108 | 0.1355 | 0.1082 |
| Peroxisomes | 0.0061 | 0.0003 | 0.0009 | 0.0026 | 0.0003 | 0.0006 | 0.0018 | 0.0001 | 0.0045 | 0.0001 | 0.0056 | 0.0003 | 0.0143 | 0.0001 | 0.0003 | 0.0013 | 0.0028 | 0.0033 |
| Punctate Nuclear | 0.0722 | 0.0485 | 0.0357 | 0.0298 | 0.1166 | 0.0728 | 0.0205 | 0.0096 | 0.0027 | 0.0029 | 0.1101 | 0.0125 | 0.0313 | 0.0096 | 0.0116 | 0.0024 | 0.0685 | 0.0419 |
| Vacuole | 0.0022 | 0.0025 | 0.0011 | 0.008 | 0.0008 | 0.0009 | 0.0034 | 0.0007 | 0.0024 | 0.0003 | 0.0062 | 0.0004 | 0.0017 | 0.0026 | 0.0017 | 0.0054 | 0.0038 | 0.0006 |
| Vacuole Periphery | 0.001 | 0.0005 | 0.0003 | 0.0021 | 0.0005 | 0.0002 | 0.002 | 0.0001 | 0.0011 | 0 | 0.0116 | 0.0002 | 0.0008 | 0.0002 | 0.0002 | 0.0027 | 0.0021 | 0.0006 |
Sequencing Data
| R1 | R2 | |||||||||
|---|---|---|---|---|---|---|---|---|---|---|
| G1 Post-START | S/G2 | Metaphase | Anaphase | Telophase | G1 Post-START | S/G2 | Metaphase | Anaphase | Telophase | |
| Gene Expression | 27.735 | 26.357 | 23.5359 | 11.6731 | 20.0856 | 12.9858 | 16.8253 | 8.8409 | 7.0019 | 15.7018 |
| Translational Efficiency | 0.7662 | 0.7503 | 0.6285 | 0.6753 | 0.6355 | 0.6618 | 0.7054 | 0.7041 | 0.6742 | 0.6998 |
Hit Data
| Dataset | Hit |
|---|---|
| Protein Concentration | ✘ |
| Protein Localization | ✘ |
| Gene Expression | ✔ |
| Translational Efficiency | ✘ |
Endocytosis
| Temp | Actin Patch (Sac6-tdTomato) | Cortical Patch (Sla1-GFP) | Late Endosome (Snf7-GFP) | Vacuole (Vph1-GFP) |
|---|---|---|---|---|
| 37℃ | ||||
| RT |
Cell Cycle Omics
CYCLoPs (Dhr2-GFP)
| Gene / Allele | Actin Patch (Sac6-tdTomato) | Cortical Patch (Sla1-GFP) | Late Endosome (Snf7-GFP) | Vacuole (Sac6-tdTomato) |
|---|
| Gene | Images |
|---|
| Gene | Images |
|---|
Images are not yet available
Images are not yet available